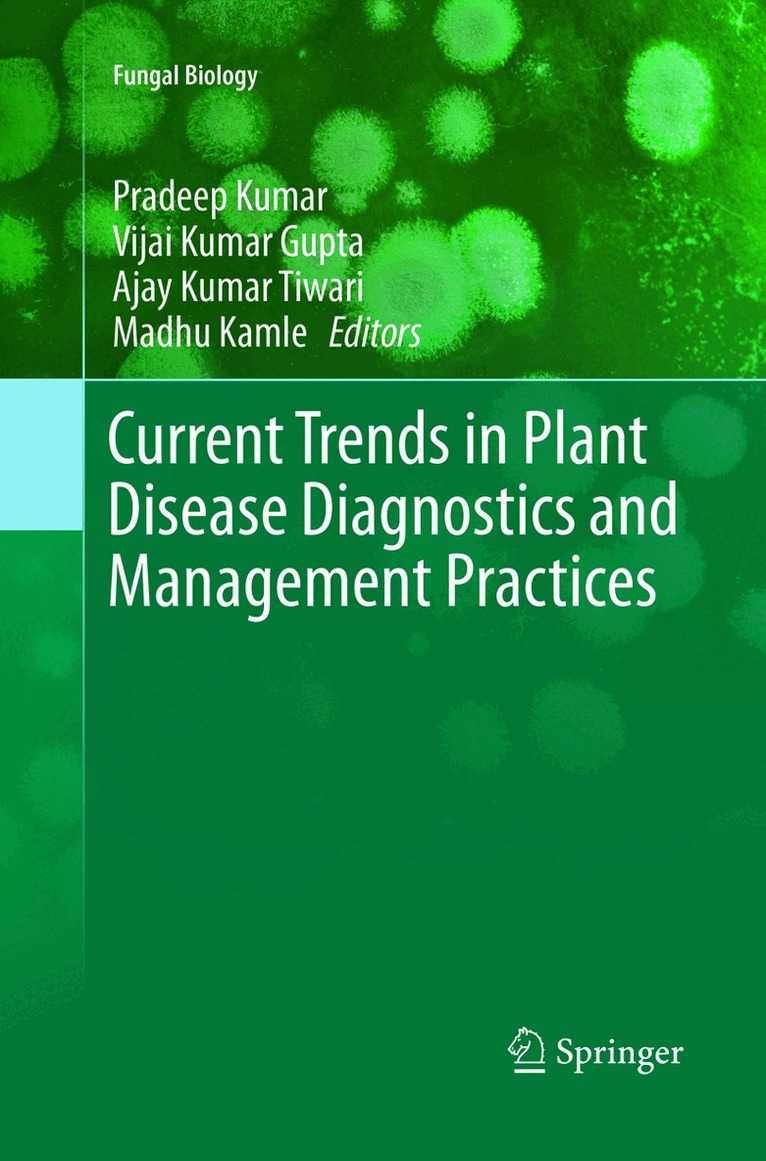

Pradeep Kumar, PhD, is Assistant Professor in the Department of Forestry, North Eastern Regional Institute of Science and Technology (deemed to be University-MHRD, Government of India), Nirjuli, Arunachal Pradesh, India. He has presented at various national and international conferences, and published books, book chapters, and over 50 research and review articles.Ajay K. Tiwari, PhD, is a Scientific Officer at the Uttar Pradesh Council of Sugarcane Research, Shahjahnapur, India. He has published research and review articles, book chapters, and edited books. He has submitted more than 150 nucleotide sequences of plant pathogens to GenBank. He is Managing Editor of the journal Sugar Tech and Chief Editor of the journal Agrica.Madhu Kamle, PhD, is Assistant Professor in the Department of Forestry, North Eastern Regional Institute of Science and Technology, Nirjuli, Arunachal Pradesh, India. She also worked as an International Research Professor at the School of Biotechnology, Yeungnam University, Gyeongsan, Republic of Korea. Dr. Kamle has published research papers, book chapters, and an edited book.Zafar Abbas, PhD, is Senior Associate Professor and Chairman in the P. G. Department of Botany at G. F. College (M. J. P. Rohilkhand University) in Shahjahanpur, Uttar Pradesh, India. He has 40 years of research experience in plant and crop physiology, with a specialization in plant nutrition. He has attended several national and international seminars and conferences, authored and edited several books, and published over 30 journal articles.Priyanka Singh, PhD, is the Scientific Officer of the Uttar Pradesh Council of Sugarcane Research, Shahjahanpur, India. She has worked at the Indian Institute of Sugarcane Research and has many years of research experience, and has organized training programs. She serves as Managing Editor for the journal Sugar Tech and as Executive Editor for the journal Agarica. Dr. Singh has authored books, book chapters, and research papers, as well as annual reports.